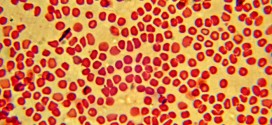

La Artritis Blenorrágica Idiopática es una enfermedad reumatológica rara del grupo de las espondilo artropatías seronegativas, que son artritis (inflamación de las articulaciones) reactivas sistémicas caracterizadas por la presencia de artritis, uretritis (inflamación de la uretra) no gonocócicas, conjuntivitis (inflamación de la conjuntiva del ojo) y lesiones de piel y mucosas. Se estima que existen 3,5-5 casos por 100.000 habitantes; …
Leer MásA
ATAXIA DE FRIEDREICH
La Ataxia de Friedreich es una enfermedad poco común que se transmite a través de las familias (hereditaria) y afecta los músculos y el corazón. La Ataxia de Friedreich es una enfermedad hereditaria que causa daño progresivo al sistema nervioso dando como resultado síntomas que varían desde perturbaciones de la marcha y problemas del lenguaje a la enfermedad cardíaca. La …
Leer MásABSCESOS GRASOS
Los abscesos grasos. Tumor, quiste, etc; normalmente es benigno constituido por una masa circunscrita de tejido adiposo ó constituidos por la proliferación de tejido celular subcutáneo. Es un tumor, quiste, absceso, etc; benigno compuesto de tejido adiposo, a veces encapsulado que se manifiestan como masas redondas bien definidas con una pared visible y homogénea. Tiene un crecimiento lento de masa …
Leer MásALCAPTONURIA HOMOGENTISICA HEREDITARIA
La Alcaptonuria Homogentísica Hereditaria es una enfermedad hereditaria muy rara caracterizada por una tríada típica: excreción de grandes cantidades de orina de color oscuro, ocronosis (pigmentación del tejido conjuntivo) y artrosis degenerativa de las grandes articulaciones. Es una rara enfermedad del tipo autosomal recesivo que afecta al metabolismo de la tirosina. Los pacientes que padecen de esta condición acumulan acido …
Leer MásAFTOSIS DE TOURAINE
La Aftosis de Touraine es una enfermedad multisistémica inflamatoria crónica (que tiene un curso prolongado por mucho tiempo) rara, de causa desconocida, caracterizada por la tríada de uveítis (inflamación de una membrana que recubre ciertas partes de los ojos, llamada úvea), úlceras bucales y de los órganos genitales recurrentes y artritis (inflamación de las articulaciones). Aunque se desconoce la causa, …
Leer MásACROCEFALOSINDACTILIA
La Acrocefalosindactilia es una enfermedad genética hereditaria muy rara, caracterizada por craneosinostosis (cierre prematuro de las suturas), exoftalmos (protrusión anormal del globo del ojo grave), pulgares y dedos anchos y cortos, sindactilia (fusión congénita o accidental de dos o más dedos entre sí), turribraquicefalia (cabeza con vértice puntiagudo), asimetría craneofacial, hipoplasia (desarrollo incompleto o defectuoso) maxilar, hipertelorismo (aumento de la …
Leer MásARTRITIS ACRONOTICA
La Artritis acronótica es una enfermedad hereditaria muy rara caracterizada por una tríada típica: excreción de grandes cantidades de orina de color oscuro, ocronosis (pigmentación del tejido conjuntivo) y artrosis degenerativa de las grandes articulaciones. Es una rara enfermedad del tipo autosomal recesivo que afecta al metabolismo de la tirosina. Los pacientes que padecen de esta condición acumulan acido homogentísico …
Leer MásATROFIA ESPINAL PROGRESIVA
La Atrofia Espinal Progresiva. Es un grupo de trastornos de las neuronas motoras (células motoras). Estos trastornos son hereditarios y pueden aparecer en cualquier etapa de la vida. El trastorno lleva a debilidad y atrofia muscular. Esto ocurre debido a la afectación de las neuronas motoras de la médula espinal, que hace que el impulso nervioso no se pueda transmitir …
Leer MásAMIOTROFIA BULBOESPINAL
La Amiotrofia Bulboespinal, es una enfermedad rara del grupo de enfermedades de la motoneurona, provoca atrofia muscular por afectación de la motoneurona inferior. Es una enfermedad rara de la neurona motora, de herencia recesiva ligada al X, caracterizada por una pérdida de masa muscular proximal y bulbar. Se hereda ligada al cromosoma X por lo que los pacientes son siempre …
Leer MásADRENOMIELONEUROPATIA DEL ADULTO
La Adrenomieloneuropatía del adulto, es lentamente progresiva y afecta al hombre adulto, adulto joven, o incluso un hombre mayor, es decir, aquellos pacientes que alcanzaron un nivel de vida de tantos años o vejez alcanzado. Esta enfermedad se caracteriza por paraparesia, lentamente progresiva, acompañada de incontinencia o retención urinaria, impotencia, neuropatía periférica, sobre todo en las extremidades inferiores. Más información …
Leer MásADRENOLEUCODISTROFIA
La Adrenoleucodistrofia por lo regular se trasmite de padres a hijos como un rasgo genético ligado al cromosoma X. Por lo tanto, afecta sobre todo a los hombres, aunque algunas mujeres portadoras pueden tener formas más leves de la enfermedad. Es una enfermedad genética ligada al cromosoma X que puede comenzar en la infancia, en la adolescencia o en la …
Leer MásATAXIA ESPINOCEREBELOSA (SCA3)
La Ataxia Espinocerebelosa (SCA3) se caracteriza por ataxia cerebelar progresiva. Como en todas las formas de ataxia, el primer síntoma normalmente es el deterioro de las capacidades para mantener el equilibrio, seguido después por incoordinación en las manos o dificultades en el habla (disartria). Algunos pacientes notan visión doble. Para el médico la apariencia de los ojos puede ser una …
Leer MásACIDURIA HOMOGENTISICA
La Acidura Homogentísica es una enfermedad hereditaria muy rara caracterizada por una tríada típica: excreción de grandes cantidades de orina de color oscuro, ocronosis (pigmentación del tejido conjuntivo) y artrosis degenerativa de las grandes articulaciones. Es una rara enfermedad del tipo autosomal recesivo que afecta al metabolismo de la tirosina. Los pacientes que padecen de esta condición acumulan acido homogentísico …
Leer MásATROFIA MUSCULAR ESPINAL
La atrofia muscular espinal (AME) o amiotrofia espinal es un grupo de diferentes enfermedades musculares. Tomadas en grupo, es la segunda causa principal de enfermedad neuromuscular, después de la distrofia muscular de Duchenne. La atrofia muscular espinal (AME) es una enfermedad genética que ataca las células nerviosas llamadas neuronas motoras que se encuentran en la médula espinal. Estas neuronas se …
Leer MásATROFIA MUSCULAR PROGRESIVA
La atrofia muscular progresiva es un trastorno hereditario que afecta a los nervios que controlan la actividad del cuerpo (enfermedad de neurona motora). En la atrofia muscular progresiva ocurre deterioro (degeneración) de las células del asta anterior de la médula espinal, los núcleos motores de los pares craneales inferiores, y las vías corticospinal y cortico bulbar. La atrofia muscular progresiva …
Leer MásARTRITIS CRONICA
La artritis crónica involucra la degradación del cartílago, el cual normalmente protege una articulación, permitiendo que ésta se mueva de forma suave. El cartílago también absorbe el golpe cuando se ejerce presión sobre la articulación, como sucede cuando uno camina. La artritis crónica aparece lentamente, se mantiene durante mucho tiempo y suele provocar alteraciones de la articulación. Se acompaña de …
Leer MásANEMIA HEMOLITICA EXTRACORPUSCULAR
La anemia hemolítica extracorpuscular. La anemia hemolítica de causa extracorpuscular constituye un grupo heterogéneo de entidades, caracterizadas por un acortamiento en la vida media del hematíe por debajo del rango normal de 100-120 días. La causa es siempre adquirida ajena al eritrocito, que presentará características formativas y funcionales rigurosamente normales. El término hemólisis significa reducción de la vida media eritrocitaria, …
Leer MásANEMIA HEMOLITICA ENZIMOPRIVA
Anemia hemolítica enzimopriva o por enzimopatía. Es una variedad de anemia hemolítica hereditaria no esferocitica, de transmisión dominante ligada al sexo. Se caracteriza a la ausencia en los glóbulos rojos de una de las enzimas necesarias para su metabolismo: bien de una enzima del ciclo del glutatión (glucosa – 6 -fosfato-deshidrogenasa o G – 6 – FD especialmente, 6- fosfogluconato-deshidrogenasa …
Leer MásANEMIA HEMOLITICA ENZIMA DEFICIENTE
La anemia hemolítica enzima deficiente. Es la más conocida es la que se origina por una deficiencia de la actividad de la enzima glucosa 6-fosfato deshidrogenasa. Este tipo deficiencia produce un déficit de NADPH, agente reductor generado por el ciclo de las pentosas, que se requiere para mantener el glutatión en estado reducido, mediante la glutatión reductasa. En el eritrocito …
Leer MásANEMIA HEMOLITICA AUTOINMUNE
Las anemias hemolíticas autoinmunes (AHAI) son resultado de la reducción de la vida del eritrocito por mecanismos inmunológicos e incremento de la hemólisis, que en condiciones normales es de 1 %. No siempre se presenta un cuadro anémico, ya que la médula ósea tiene la capacidad de aumentar la producción de eritrocitos logrando compensar la destrucción; el resultado es un …
Leer Más Binipatia e higienismo Medicina natural alternativa, plantas medicinales y remedios caseros naturales
Binipatia e higienismo Medicina natural alternativa, plantas medicinales y remedios caseros naturales